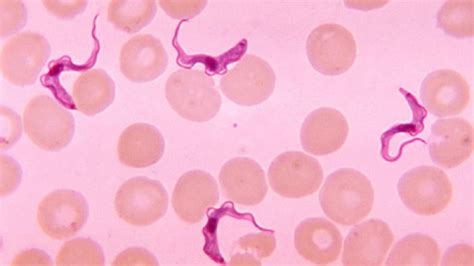

Sleeping Sickness Explained: Causes, Symptoms, Treatment
Unveiling Sleeping Sickness: Your Essential Guide To African Trypanosomiasis
Hey there, folks! Ever heard of something called sleeping sickness ? Sounds pretty benign, right? Like maybe you just get a bit extra sleepy. Well, let me tell you, this isn’t your average nap-time dilemma . We’re talking about a serious, life-threatening parasitic infection also known as African Trypanosomiasis . It’s a disease that, if left untreated, literally messes with your brain and nervous system, eventually leading to coma and, tragically, death. Scary stuff, I know, but understanding it is the first step to staying safe and helping others. So, buckle up, guys, because we’re going to dive deep into what this disease is all about, how it spreads, what signs to look out for, and most importantly, how we can fight it. This isn’t just about dropping some medical jargon; it’s about giving you the real talk, the crucial information you need to comprehend the gravity of sleeping sickness, its impact on communities, and the ongoing global efforts to control and eliminate it. We’ll explore its origins, the unique ways it manifests, and the remarkable scientific advancements that have brought us closer to managing this ancient foe. Trust me, by the end of this, you’ll be much more clued-in about this often-misunderstood condition, moving beyond just the catchy name to grasp the true complexity of African Trypanosomiasis.
Table of Contents
What Exactly is Sleeping Sickness? Understanding the Basics
Alright, let’s kick things off by getting a proper grip on what sleeping sickness actually is. Officially, as I mentioned, it’s called African Trypanosomiasis , and it’s a parasitic disease specific to sub-Saharan Africa. It’s caused by a nasty little parasite called Trypanosoma brucei and, here’s the kicker, it’s transmitted to humans through the bite of an infected tsetse fly . Imagine a fly, a bit bigger than your common housefly, lurking in rural areas, especially near rivers and dense vegetation. That’s our main vector, the little guy carrying the infection. This disease isn’t some new kid on the block; it’s been a scourge in Africa for centuries, causing devastating epidemics and severely impacting public health and economic development in affected regions. Historically, it has wiped out entire villages and continues to pose a significant threat, though efforts to control it have made considerable progress. Understanding its geography is key: it’s not everywhere in Africa, but rather concentrated in specific areas where the tsetse fly thrives and the parasite circulates. There are two main forms of human African trypanosomiasis (HAT), and knowing the difference is super important for diagnosis and treatment. First, we have Trypanosoma brucei gambiense (T.b. gambiense), which causes the chronic form of the disease. This is the more common type, accounting for over 98% of reported cases, and it’s found in central and western Africa. This form can sneak up on you, progressing slowly over months or even years, making it tricky to diagnose early. Then there’s Trypanosoma brucei rhodesiense (T.b. rhodesiense), which causes the acute form. This one is found in eastern and southern Africa and is far more aggressive, developing rapidly over weeks or a few months. Both forms are serious, but their progression rates significantly influence how they’re identified and managed by medical professionals. So, when we talk about sleeping sickness , we’re talking about a complex disease with different geographical strongholds and different paces of progression, all starting with that one pesky tsetse fly bite. Knowing these fundamental facts is absolutely critical for anyone wanting to understand or, even better, contribute to the fight against this debilitating illness. It’s not just a single entity, but a multifaceted challenge that requires a nuanced approach, acknowledging its various forms and impacts on human health. This initial understanding lays the groundwork for appreciating the subsequent discussions on its transmission, symptoms, diagnosis, and ultimately, its control and prevention. It’s a testament to how seemingly small biological interactions can have such monumental effects on human populations, underscoring the urgent need for continued research and public health initiatives in these vulnerable regions. Think of it, guys, like an insidious biological clock ticking differently depending on the type of parasite involved, demanding varied responses from healthcare systems and communities alike. This is why awareness, accurate information, and sustained global health efforts are not just helpful, but absolutely essential in tackling sleeping sickness head-on.
The Nasty Culprit: How Sleeping Sickness Spreads and Its Forms
Okay, guys, let’s get down to the nitty-gritty of how this whole nightmare, sleeping sickness , actually makes its way into our bodies. As we touched on, the main vector is the infamous tsetse fly , specifically species from the genus Glossina . These flies aren’t just annoying; they’re the ferrymen for the Trypanosoma brucei parasite. Imagine this: an infected tsetse fly takes a blood meal from a human or an animal that carries the parasite. Inside the fly, the parasites multiply and develop, eventually migrating to the fly’s salivary glands. Then, when this now-infected fly bites another unsuspecting human or animal, it injects these parasites into the bloodstream, and boom, the infection has a new host. It’s a pretty cunning life cycle, ensuring the parasite’s survival and spread. What’s really fascinating, and a bit scary, is that not all tsetse flies are infected, and not every bite from an infected fly will transmit the disease. However, the risk is always there in endemic areas. Beyond the primary transmission via the tsetse fly, there have been rare instances of other transmission routes, such as mother-to-child transmission, accidental infections in laboratories (super rare, thankfully!), and even sexual transmission, though these are extremely uncommon compared to the fly-borne method. But let’s zoom in on those two forms of human sleeping sickness because they behave quite differently and understanding this is crucial for anyone involved in diagnosis or public health. We have Trypanosoma brucei gambiense ( T.b. gambiense ). This form is typically found in western and central Africa and is characterized by its chronic progression. When someone gets infected with T.b. gambiense , the initial symptoms can be really mild and non-specific, making it easy to miss. We’re talking about general malaise, headaches, maybe a low-grade fever that comes and goes. The parasites can hang out in the blood and lymph for months, or even years, before they decide to cross the blood-brain barrier and invade the central nervous system (CNS). This slow progression is a double-edged sword: it gives healthcare providers a wider window for diagnosis and treatment before the disease becomes severe, but it also means people can be unknowingly infected for a long time, acting as reservoirs for the parasite and spreading it to others. Then there’s Trypanosoma brucei rhodesiense ( T.b. rhodesiense ), prevalent in eastern and southern Africa. This type is the acute one, and it means business. The disease progresses much faster, usually within weeks to a few months after infection. The symptoms are more severe and appear earlier. The parasites invade the CNS more rapidly, leading to the neurological stage much quicker than its gambiense cousin. This rapid onset makes early diagnosis and swift treatment absolutely critical, as the window for effective intervention before severe complications arise is much narrower. Moreover, T.b. rhodesiense primarily affects wild and domestic animals (like cattle), which act as significant reservoirs for the parasite, making control efforts more challenging compared to the largely human-centric T.b. gambiense cycle. So, while both forms are equally dangerous if untreated, their epidemiological characteristics, geographic distribution, and clinical progression demand different approaches to surveillance, diagnosis, and treatment strategies. This deeper understanding of the tsetse fly , the parasite’s journey, and the distinct behaviors of gambiense and rhodesiense forms is paramount for anyone keen on grasping the full scope of sleeping sickness and the intricate challenges it presents to global health.
Spotting the Signs: Symptoms of Sleeping Sickness
Alright, guys, this is where we get into the really critical stuff: what to look out for if you or someone you know might have sleeping sickness . Because the symptoms can be a bit sneaky, especially in the early stages, it’s super important to be aware. Remember, we talked about two forms of the disease ( gambiense and rhodesiense ), and while they both lead to the same tragic outcome if untreated, the speed at which symptoms appear can differ wildly. Generally, the disease progresses in two distinct stages, and knowing these stages is key to understanding the full picture of African Trypanosomiasis.
Stage 1: The Haemolymphatic Stage (The Early Stage)
This is the initial phase, where the parasites are primarily circulating in the blood and lymph system. It can last for months or even years with T.b. gambiense , or just weeks with the more aggressive T.b. rhodesiense . The symptoms here can be pretty vague, making them easy to mistake for other common illnesses like malaria or the flu. That’s why early detection is so challenging but absolutely vital. The classic early signs often include:
- Fever: This isn’t usually a constant, raging fever. It often comes and goes, in an intermittent pattern, which can be confusing.
- Headache: Persistent and often severe headaches are a common complaint.
- Joint Pain: Aches and pains in the joints, sometimes migratory, can make you feel generally unwell.
- Itching: Intense, generalized itching (pruritus) is surprisingly common in the early stages, especially with gambiense form. It’s often overlooked but can be a tell-tale sign.
- Swollen Lymph Nodes: This is a pretty significant one, especially in T.b. gambiense infections. You might notice enlarged, firm, and often non-tender lymph nodes, particularly in the back of the neck. This specific symptom is so characteristic it has its own name: Winterbottom’s sign . If you see this, especially in someone who has been in an endemic area, it should raise a serious red flag.
- Skin Lesion (Chancre): Sometimes, a painful, reddish sore called a trypanosomal chancre can develop at the site of the tsetse fly bite. This usually appears a few days after the bite and can persist for a couple of weeks before healing. It’s not always present, but when it is, it’s a very clear indicator.
During this first stage, people often don’t feel sick enough to seek medical attention immediately, especially if the symptoms are mild or intermittent. This is particularly true for T.b. gambiense , where a person can be infected for a long time without severe symptoms, unknowingly spreading the disease if they are bitten by more tsetse flies. But even if the symptoms seem minor, the parasites are multiplying and silently preparing for their next, more devastating move.
Stage 2: The Neurological Stage (The Late Stage)
This is where sleeping sickness really earns its name and becomes truly terrifying. In this stage, the parasites have crossed the blood-brain barrier and invaded the central nervous system (CNS). This leads to a whole host of neurological and psychiatric symptoms, turning the disease into a grave threat. The progression into this stage marks a critical point, as treatment becomes more complex and the risk of irreversible damage increases significantly. Symptoms here are far more severe and unmistakable:
- Confusion and Disorientation: People might become disoriented, struggle with basic tasks, or seem generally confused about their surroundings or even their identity.
- Poor Coordination: Difficulty with balance, walking, and fine motor skills (ataxia) becomes noticeable. This can manifest as an unsteady gait or clumsiness.
- Behavioral Changes: You might see dramatic shifts in personality, including irritability, aggression, psychosis, or an unusual apathy. These changes can be distressing for both the patient and their loved ones.
- Sleep-Wake Cycle Disturbances: This is the hallmark symptom, the one that gives the disease its name. Patients experience severe disruptions in their natural sleep patterns. They might suffer from insomnia at night, struggling to get any rest, followed by overwhelming, uncontrollable drowsiness during the day. They might fall asleep at inappropriate times, hence